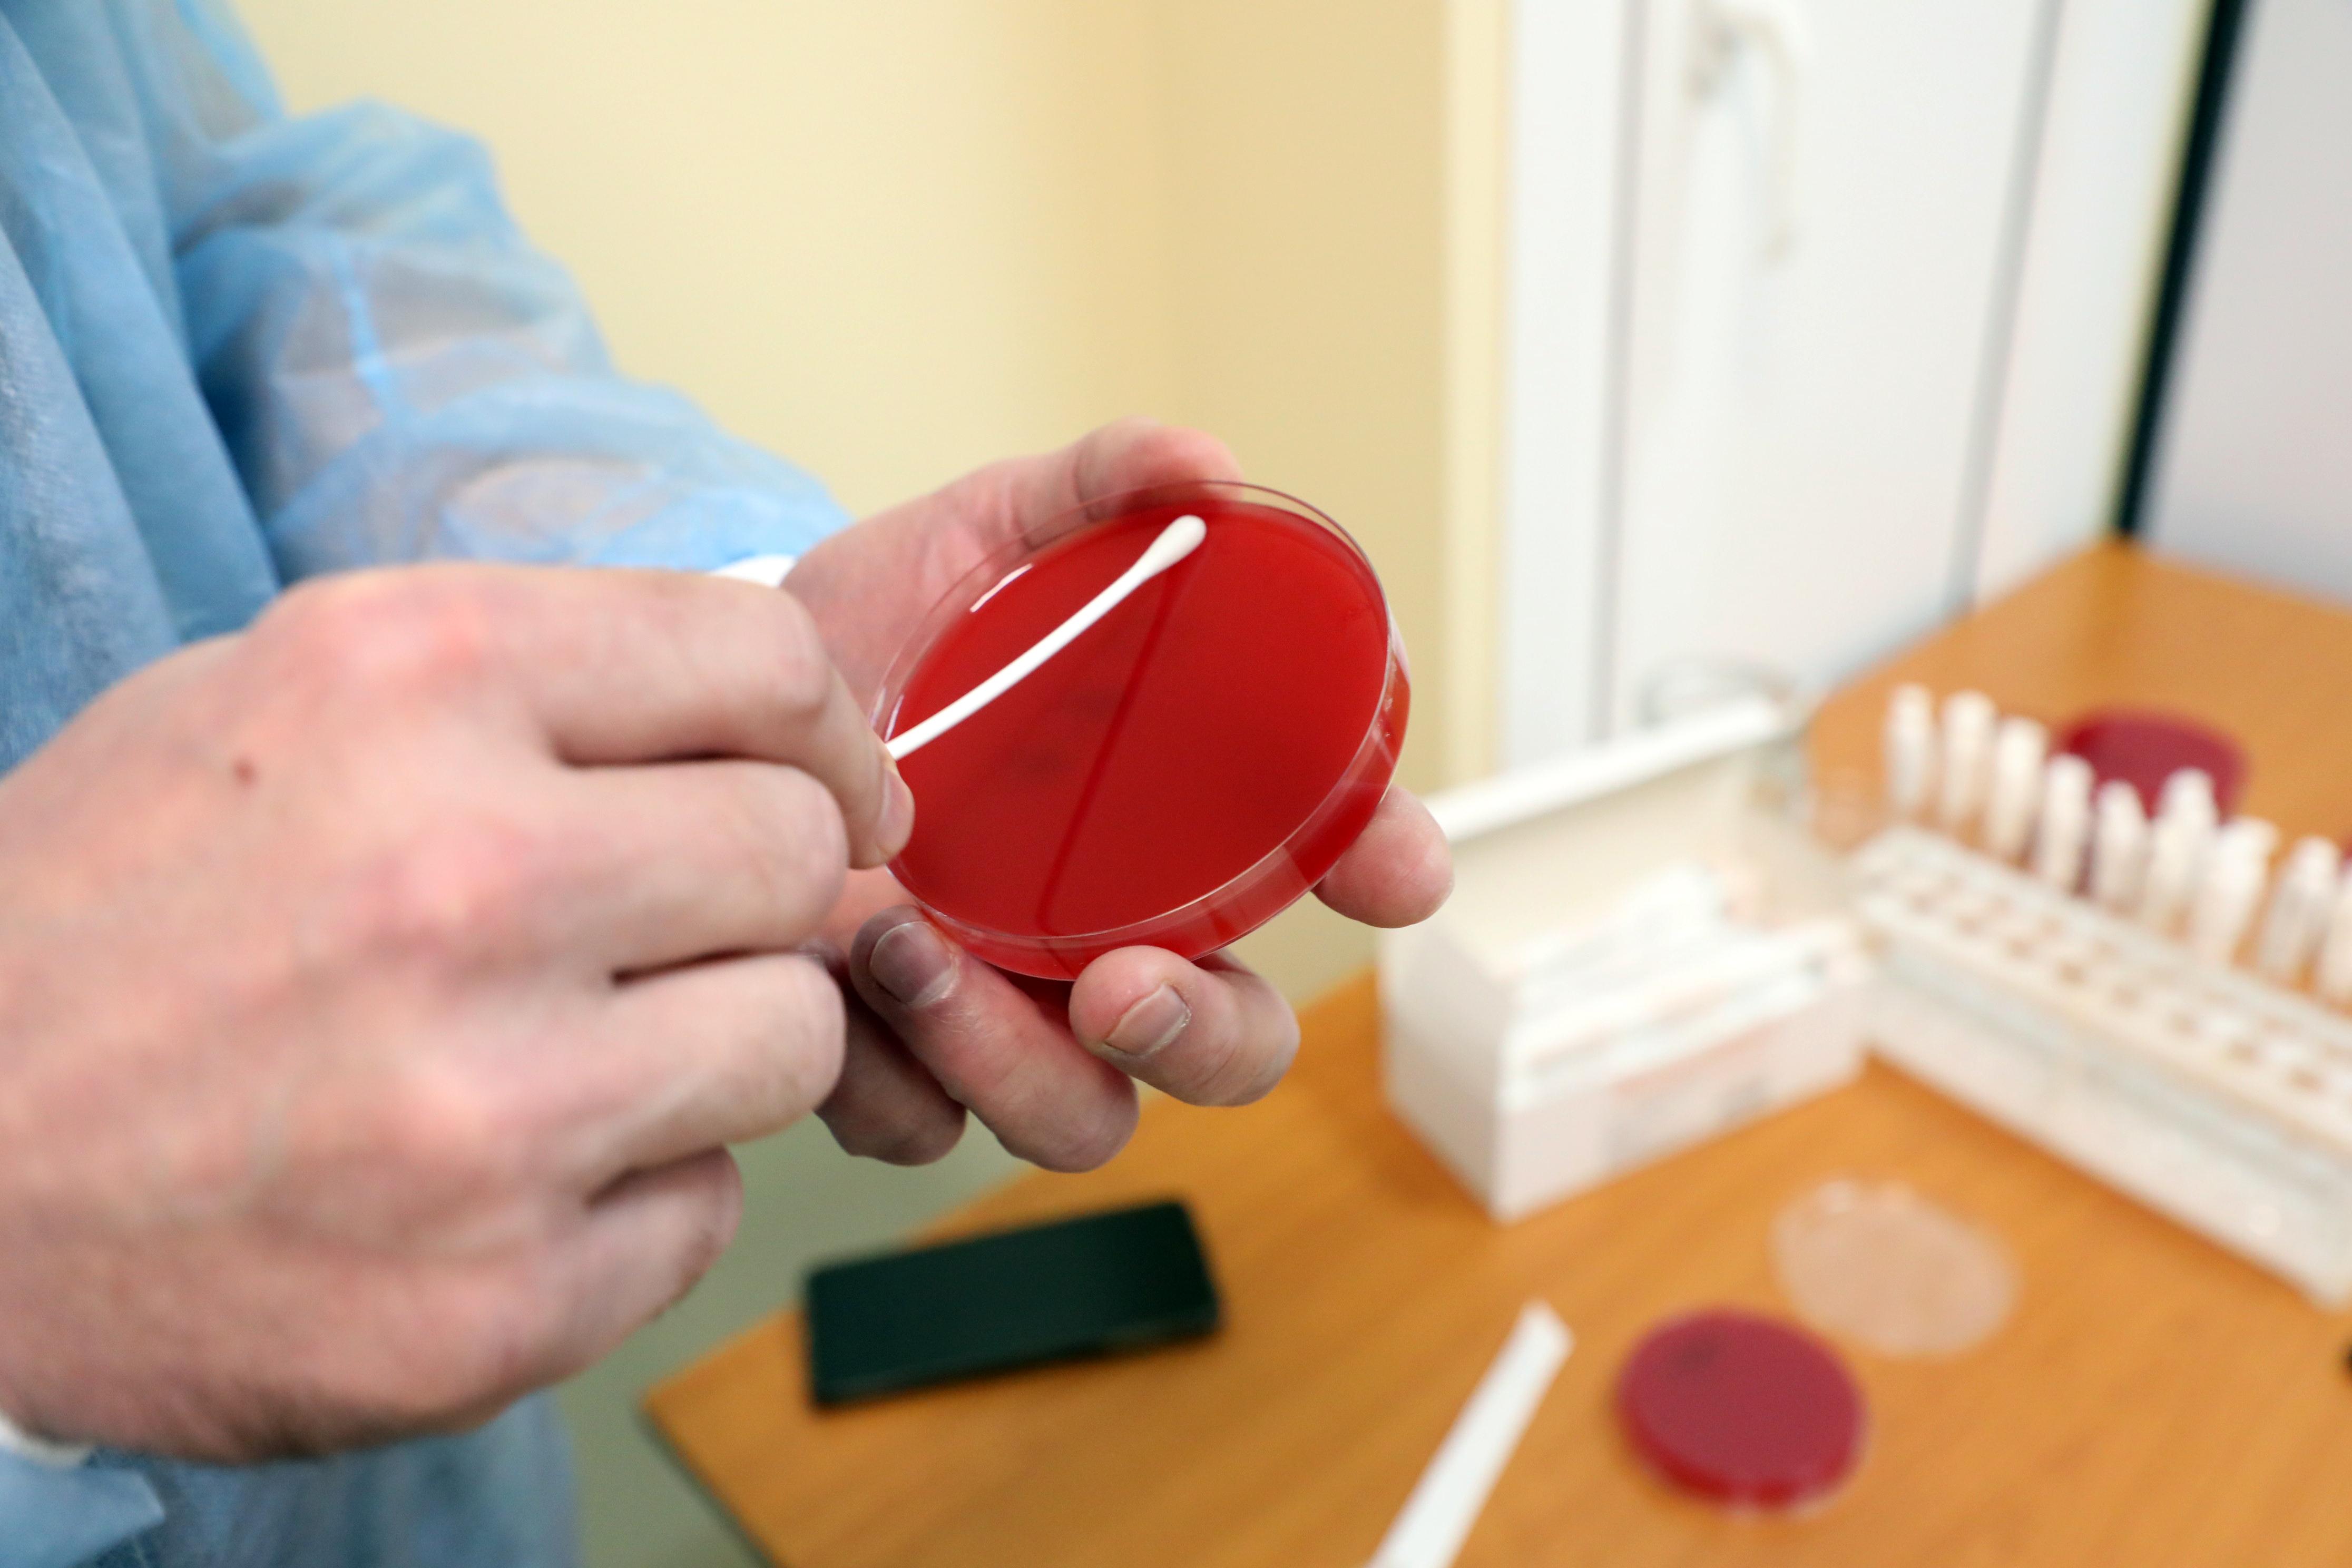

Волгоградские медики предупреждают об опасности телефонов
Специалисты Волгоградского государственного медицинского университета заявили, что мобильные телефоны могут быть источником смертельных инфекций. Для заражения достаточно просто взять устройство в руки.
30 марта, 2026, 17:18 15

Инфекция может проникнуть в организм при простом взятии телефона в руки.
Источник:
Учёные ВолгГМУ обратили внимание на скрытую угрозу, исходящую от мобильных телефонов. По их данным, контакт с устройством способен привести к проникновению в организм опасных патогенов.
Золотистый стафилококк и синегнойная палочка выделяются как наиболее опасные патогены.
Источник:
На поверхности гаджетов могут обитать различные микроорганизмы, в том числе крайне опасные золотистый стафилококк и синегнойная палочка. Эти бактерии способны вызвать сепсис и другие тяжёлые заболевания.

Регулярная обработка телефона антисептиком минимум дважды в день помогает снизить риски.
Источник:
«Обнаружены не только привычные микробы, представляющие нормальную микробиоту человека, но и клинически значимые патогенные штаммы — золотистый стафилококк и синегнойная палочка. Последняя, кстати, считается одной из самых опасных бактерий, поскольку способна размножаться даже на туалетном мыле и приводить к тяжелым инфекционным заболеваниям, включая пневмонию с летальным исходом», — рассказала заведующий кафедрой микробиологии ВолгГМУ, главный внештатный специалист Минздрава России по медицинской микробиологии ЮФО, доктор медицинских наук Ирина Степаненко.
По словам эксперта, бактерии попадают на телефоны через повседневные контакты: рукопожатия, прикосновения к дверным ручкам, а также воздушно-капельным путём. Микроорганизмы способны выживать на поверхности устройства несколько суток, особенно активно накапливаясь в щелях между корпусом и чехлом, куда затруднён доступ при обычной чистке.
«Телефон во время использования человеком, особенно учитывая воздух закрытых помещений, становится фактором распространения опасных штаммов, которые не всегда поддаются лечению из-за устойчивости к антибиотикам», — подчеркнула доктор Степаненко.
В качестве профилактики медики советуют не менее двух раз в день обрабатывать гаджеты спиртосодержащими салфетками или антисептиками. Также необходимо мыть руки не только перед едой, но и после любого контакта с людьми, поверхностями в общественных местах и самими электронными устройствами.
Читайте также





















